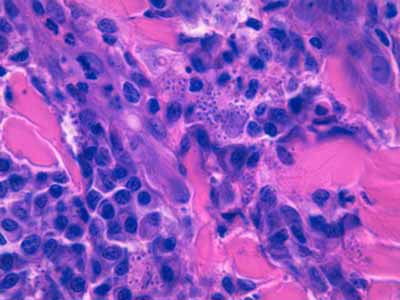

Décembre 2011
Auteurs :
Frédérique Degorce-Rubiales1 – CES de Dermatologie Vétérinaire, DESV d’Anatomie Pathologique Vétérinaire, Spécialiste en Anatomie Pathologique Vétérinaire
Agnès Poujade1 – DESV d’Anatomie Pathologique Vétérinaire, Spécialiste en Anatomie Pathologique Vétérinaire
1LAPVSO – 129 Route de Blagnac – 31201 Toulouse cedex 2 – www.lapvso.com
Avertissement
Le cas clinique présenté est un cas de dermatopathologie, aussi l’anamnèse, l’examen clinique, l’examen dermatologique et les examens complémentaires réalisés, se limiteront aux données présentes sur la fiche de commémoratifs reçue avec les prélèvements histologiques.
Commémoratifs
Une chienne American Staffordshire terrier, âgée de 3 ans est présentée à la consultation pour échec d’un traitement antibiothérapique administré après le diagnostic initial d’une folliculite. Le propriétaire signale une baisse de forme récente.
Examen général
L’examen général détecte une adénomégalie modérée généralisée.
Examen dermatologique
La chienne présente une dermatose généralisée papulo-pustuleuse. Le prurit est important.
Photo 1 : Atteinte des pourtours péri-orificiels de la face, du chanfrein
et des pavillons auriculaires : on note une alopécie, une hyperpigmentation,
un discret érythème et des lésions papulo-croûteuses parfois excoriées.
©Photo Dr Jacques Lamothe.
Photo 2 : Atteinte de l’ensemble du corps
©Photo Dr Jacques Lamothe.
Photo 3 : Lésions papulo-pustuleuses en face interne des postérieurs
©Photo Dr Jacques Lamothe.
Photo 4 : Lésions papulo-croûteuses et discret squamosis pityriasiforme amiantacé
©Photo Dr Jacques Lamothe.
Photo 5 : Lésions papulo-croûteuses excoriées et collerettes épidermiques
©Photo Dr Jacques Lamothe.
Photo 6 : Lésion pustuleuse
©Photo Dr Jacques Lamothe.
Hypothèses cliniques
- Leishmaniose
- Pyodermite superficielle sur éventuel contexte allergbologique
- Pemphigus foliacé
Examens complémentaires
- Raclages cutanés et trichogramme ne révèlent aucun élément figuré, ni anomalie folliculaire.
- Immunoélectrophorèse (Photo 7) : en vert les valeurs anormales
- Pt 77 g/l A/G 0.36 (Valeurs usuelles VU 60-80) (VU 0,5-1,2)
- Alb 23.3% 20.3 g/l (VU 25-35)
- Alpha 1 2.8% 2.2 g/l ((VU 5-8)
- Alpha 2 17.2 % 13.2 g/l (VU 5-10)
- Beta 36.3 % 27.9 g/l ((VU 7-12)
- Gamma 17..4% 13. 4 g/l ((VU 5-15)
Photo 7 : Immunoélectrophorèse des protéines sériques
©Photo Dr Jacques Lamothe.
- Un test leishmaniose rapide s’avère négatif.
- La sérologie (ELISA) est positive
- Des biopsies cutanées sont réalisées pour analyse histopathologique
Examen histologique
A l’examen histologique, on observe des pustules intra-épidermiques, sous-cornées, planes, extensives, pontant l’abouchement de plusieurs follicules pileux voisins (Photo 1,2) et pouvant contenir des cellules épithéliales acantholytiques (Photo 10,11,12,13). Leur plancher épidermique montre une forte exocytose éosinophilique (Photo 10,11,12,13). Le derme est le siège d’un infiltrat inflammatoire de topographie périvasculaire (Photo 8,9), riche en macrophages, granulocytes éosinophiles et plasmocytes. Certains macrophages contiennent dans leur cytoplasme un élément rond à ovalaire, bi-polaire de quelques micromètres de diamètre, dont la silhouette est fortement compatible avec un parasite protozoaire du genre Leishmania (Fig14).
Photo 8 (Hémalun Eosine X 40) : L’épiderme est parsemé de vésiculo-pustules sous-cornées,
extensives, planes, dont le toit, composé de fines lamelles de kératine orthokératosique, est fragile.
Le derme montre un infiltrat de topographie péri-vasculaire.
Le patron lésionnel est celui d’une dermatite psutuleuse sous-cornée périvasculaire.
Légendes de la Photo 8 :
- Pointe de flèche turquoise : pustule intra-épidermique sous-cornée
- Flèche orange : infiltrat dermique de topographie péri-vasculaire
- Étoiles rouges pleines : vaisseaux sanguins
- Étoiles rouges vides : follicules pileux
Photo 9 (Hémalun Eosine X 40) : Les pustules sous-cornées qui parsèment l’épiderme,
peuvent ponter l’abouchement de plusieurs follicules pileux voisins.
Légendes de la Photo 9 :
- Double flèche noire : épiderme
- Double flèche pointillée noire : derme
- Pointes de flèche turquoise : délimitation de la pustule intra-épidermique sous-cornée qui ponte l’abouchement de trois unités folliculo-sébacées
- Pointes de flèche jaune : toit rompu de la pustule (fines lamelles de kératine orthokératosique)
- Cercles marrons : glandes sébacées
- Étoiles rouges pleines : vaisseaux sanguins
- Étoiles rouges vides : follicules pileux
- Étoiles turquoises : glandes sudorales apocrines épitrichiales
- Flèche orange : infiltrat dermique de topographie péri-vasculaire
Photo 10 (Hémalun-Eosine X200) : Vue rapprochée d’une pustule intra-épidermique sous-cornée :
son toit est fragile formé de fines lamelles de kératine; son plancher épidermique
est spongiotique et siège d’une forte exocytose de cellules inflammatoires, conduisant
à la formation de pustules micro-loculaires qui confluent en position sous-cornée;
La pustule sous-cornée contient des granulocytes et quelques cellules épithéliales.
Légendes de la Photo 10 :
- Pointes de flèche jaune : toit de la pustule intra-épidermique sous-cornée, composé de fines lamelles de kératine orthokératosique alvéolaire
- Étoiles rouges évidées : vaisseaux sanguins capillaires
- Flèche orange : infiltrat inflammatoire dermique de topographie péri-vasculaire
- Pointes de flèche turquoise : elles délimitent le contour du plancher de la pustule intra-épidermique sous-cornée
- Étoiles vertes évidées : pustules micro-loculaires qui confluent en position sous-cornée pour former la pustule dont le plancher est matérialisé par les pointes de flèches turquoises
- Cercle orange : zone d’épiderme spongiotique (spongiose ou œdème intercellulaire)
- Double flèche rouge : épiderme
- Double flèche pointillée rouge : derme
Photo 11 (Hémalun-Eosine X400) : Vue rapprochée d’une pustule intra-épidermique sous-cornée :
son toit est fragile formé de fines lamelles de kératine; son plancher épidermique
est le siège d’une forte exocytose de cellules inflammatoires; elle renferme
des granulocytes et quelques cellules épithéliales arrondies de type acantholytique.
Légendes de la Photo 11 :
- Pointes de flèche jaune : toit de la pustule intra-épidermique sous-cornée, composé de fines lamelles de kératine orthokératosique alvéolaire
- Étoile rouge évidée : cellule épithéliale acantholysée (la plus grande
- Pointes de flèche turquoise : elles délimitent le contour du plancher de la pustule intra-épidermique sous-cornée
- Flèche orange : spongiose ou œdème intercellulaire
- Étoiles vertes évidées : granulocytes dans le contenu de la pustule et en cours d’exocytose transépidermique dans le plancher épidermique
- Cercles jaunes : pustules micro-loculaires qui confluent en position sous-cornée pour former la pustule dont le plancher est matérialisé par les pointes de flèche turquoises
- Double flèche noire : épiderme
- Double flèche pointillée noire : derme
Photo 12 (Hémalun-Eosine X400) : Vue rapprochée du plancher d’une
pustule intra-épidermique sous-cornée : forte exocytose de granulocytes éosinohiles;
quelques cellules épithéliales s’arrondissent et se libèrent de leurs attaches
desmosomiales, rappelant une acantholyse intra-épidermique.
Légendes de la Photo 12 :
- Étoiles rouges : cellules épithéliales se détachant individuellement ou en petits groupes du plancher épidermique, leurs contours cytoplasmiques sont lisses, arrondis et leur noyau non pycnotique, suggérant une acantholyse intra-épidermique
- Étoiles vertes : granulocytes
- Double flèche noire : épiderme
- Flèches oranges : exocytose granulocytaire au sein du plancher épidermique conduisant à la formation de micro-pustules
Photo 13 (Hémalun-Eosine X1000 objectif à immersion) : Vue au fort
grossissement du plancher d’une pustule intra-épidermique sous-cornée :
forte exocytose de granulocytes éosinohiles; des cellules épithéliales de la couche
granuleuse au noyau bien visible, non pycnotique, s’arrondissent et se libèrent
de leurs attaches desmosomiales, rappelant une acantholyse intra-épidermique.
Légendes de la Photo 13 :
- Pointes de flèche jaune : toit de la pustule formée de kératine orthokératosique
- Flèche oranges : exocytose transépidermique de granulocytes éosinophiles
- Flèche jaunes : spongiose épidermique ou œdème intercellulaire
- Étoiles turquoises : granulocytes éosinophiles
- Cercles jaunes : cellules épithéliales se détachant individuellement ou en petits groupes du plancher épidermique (couche granuleuse), leurs contours cytoplasmiques sont lisses arrondis et leur noyau non pycnotique, suggérant une acantholyse intra-épidermique
- Étoiles rouges : érythrocytes
- Double flèche noire : épiderme
Photo 14 (Hémalun-Eosine X1000 objectif à immersion) : Vue au fort
grossissement de l’infiltrat inflammatoire dermique péri-vasculaire, formé de macrophages,
de plasmocytes et de granulocytes éosinophiles. Certains macrophages contiennent
un élément ovalaire de quelques micromètres de diamètre, discrètement bipolaire, dont
la silhouette apparaît compatible avec un parasite protozoaire et notamment avec le genre Leishmania.
Légendes de la Photo 14 :
- Étoile vertes : granulocytes éosinophiles
- Étoiles turquoises : plasmocytes
- Cercles jaunes : macrophages
- Pointe de flèche jaune : noyau de fibrocyte
- Flèche jaune : faisceau de fibres de collagène
- Étoiles rouges : un élément figuré est parfois visible dans le cytoplasme de macrophages, celui ciblé par l’étoile la plus épaisse apparaît nettement “bi-polaire” avec un pôle sombre (le noyau) et un pôle pâle (le cytoplasme) suggérant une forme amastigote de Leishmanie.
Diagnostic histologique
Aspect histologique d’une pustulose éosinophilique sous-cornée acantholytique, avec mise en évidence de rares éléments figurés intra-macrophagiques, suggérant une forme pustuleuse de leishmaniose cutanée.
Traitement et évolution
- Traitement : allopurinol 20 mg/kg SID
- Euthanasie de convenance au bout de 15 jours de traitement
Discussion
Les lésions cutanées de leishmaniose peuvent macroscopiquement revêtir l’aspect (1,2,3,4,5) :
- d’une dermatose exfoliante alopécique et squameuse (56 à 90,9%)
- d’ulcères (32,8 à 63,6%), d’alopécie péri-orbitaire (18%)
- d’alopécie diffuse (14%), d’onychogriphose (24 à 54,5%)
- de paronychie (13,6%), de dermatite pustuleuse stérile (1,6 à 13,6%)
- de dépigmentation nasale (4,5%)
- d’hyperkératose nasale et/ou podale (4,5%)
- de nodules (4,5 à 16,8%)
Microscopiquement, plusieurs patrons lésionnels peuvent s’observer dans la leishmaniose cutanée:
- Dermatite d’interface lichénoïde granulomateuse (Photo 15)
- Dermatite d’interface lichénoïde et périannexielle granulomateuse (Photo 16) avec péri-folliculite et adénite sébacée granulomateuses (Photo 18)
- Dermatite interstitielle granulomateuse nodulaire ou diffuse (Photo 17) avec péri-folliculite et adénite sébacée granulomateuses (Photo 18)
- Dermatite périvasculaire superficielle et/ou profonde, pustuleuse, acantholytique ou non (Photo 19)
- Vascularite (Photo 20) (rare)
La composition cellulaire de l’infiltrat inflammatoire, tout particulièrement s’il s’avère riche en macrophages, plasmocytes et granulocytes éosinophiles doit inciter le pathologiste à rechercher des leishmanies intra-cellulaires dans le cytoplasme des macrophages (Photo 21 & 22).
Lorsque les lésions sont riches en éléments parasitaires, le Diagnostic histologique de leishmaniose ne pose pas de problème particulier, mais lorsque le patron lésionnel est moins classique (dermatite périvasculaire pustuleuse acantholytique ou non, ou vascularite) et /ou lorsque les lésions sont pauci-parasitaires, l’examen histologique arrivera difficilement à un diagnostic de certitude, mais plutôt à une forte suspicion histologique de leishmaniose cutanée : il faudra alors compléter l’examen histologique par d’autres examens complémentaires [Photo 23 démarche diagnostique conseillée par LeishVet guidelines for the pratical management of canine leishmaniosis, 2011 (6,7)].
Pour pallier à cet écueil, il peut être particulièrement judicieux de réaliser conjointement l’examen histologique et une PCR quantitative sur des biopsies cutanées réalisées en peau lésée (certaines biopsies sont fixées par le liquide fixateur usuel formolé pour l’examen histologique, d’autres sont simplement placées dans un tube sec, pour l’analyse moléculaire), d’autant que dans les formes cutanées séquestrées la sérologie peut s’avérer négative.
Photos 15 à 22 : Patrons lésionnels rencontrés dans les lésions histologiques de leishmaniose cutanée : Dermatite d’interface lichénoïde granulomateuse (15, HE X100), Dermatite d’interface lichénoïde et périannexielle granulomateuse (16, HE X100), Dermatite interstitielle granulomateuse nodulaire ou diffuse (Photo 17 HE X25) Péri-folliculite et adénite sébacée granulomateuses (18 HE X200), Dermatite périvasculaire superficielle et/ou profonde, pustuleuse, acantholytique ou non (19, HE X25) Vascularite (20, HE X400), Infiltrat inflammatoire riche en macrophages, plasmocytes et granulocytes éosinophiles (21 & 22, HE X1000).
Photo 23 : Démarche diagnostique de la leishmaniose canine
d’après Solano-Gallego et al : LeishVet guidelines (6,7)
Remerciements
Nos plus sincères et vifs eemerciements au Docteur vétérinaire Jacques Lamothe, Clinique vétérinaire, 1, Rond-point Antoine De St Exupéry 06510 Carrros, pour ses clichés photographiques, sa confiance et sa permission d’exploiter ce cas sur Dermavet section histopathologie.
Pour en savoir plus
À consulter sur Dermavet
Un cas de leishmaniose par Éric Florant 2011
Bibliographie
(sélection pour les aspects dermatologiques, histologiques et la démarche diagnostique)
- Koutinas AF, Scott DW, Kantos V, Lekkas S : Skin Lesions in Canine Leishmaniasis (Kala-Azar) : A clinical and Histopathological Study on 22 spontaneous Casses in Greece. Veterinary Dermatology,1992,3,121-130.
- Konto VJ, Koutinas AF : Old World Canine Leishmaniasis.Compendium, 1993,7,949-959.
- Denerolle P : Leishmaniose canine : diffilculté du diagnostic et du traitement. Pratique Médicale et Chirurgicale des Animaux de Compagnie, 1996,31,137-145.
- Ciaramella P, Oliva G, De Luna R et al : A retrospective clinical study of canine leishmaniasis in 150 dogs naturally infected by Leishmania infantum. Veterinary Record, 1997, 141,539-543.
- In : T.L. Gross, P. J. Ihrke, E. J. Walder, V. K. Affolter : Skin Diseases of the Dog and Cat : Clinical and histopathologic diagnosis. Blackwell Science Ltd, Iowa, second edition 2005, p.313-317.
- Solano-Gallego L, Koutinas A. , Miro G, Cardoso L, Pennisi MG, Ferrer L, Bourdeau P, Oliva G . Baneth G. . Directions for the diagnosis, clinical staging, treatment and prevention of canine leishmaniosis, 2009, Vet Parasitol, 165 (1-2) : 1-18.
- Solano-Gallego L, Miro G, Koutinas A, Cardoso L, Pennisi M G, Ferre L, Bourdeau P, Oliva G, Baneth G : LeishVet guidelines for the pratical management of canine leishmaniosis. Paraites and Vectors, 2011, 4, 86. http://www.parasiteandvectors.com/content/4/1/86